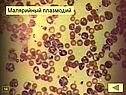

Паразиты человека |
|
Биология 7 класс
Скачать презентацию |
||
| << Внешность человека | Фрукты разных стран >> |
Биология 7 класс
краткое содержание других презентаций«Кисломолочные продукты» - Обыкновенна. Для приготовления используют цельное и пастеризованное молоко (20%, 9% жира), обезжиренное. Варенец. Домашнее задание. Технология приготовления: Молоко кипятят, охлаждают, добавляют закваску (сметана, кефир). Продукт с повышенным содержанием сухих обезжиренных веществ молока. Вырабатывается из кобыльего молока. Относится к продуктам смешанного брожения.
«Биология Паукообразные» - Паутинные бородавки. Внешнее строение пауков. Клещи. Иксодовый клещ – переносчик энцефалита. Паук-птицеед. Биология. 7 класс. Паук - крестовик. Скорпион. Класс Паукообразные. Внутреннее строение паука. Учитель биологии ГБОУ СОШ №1020 ЮЗАО г.Москвы Трушина И.А. Клещ краснотелка. Из паутины плетут кокон, в котором развиваются паучата. Таежный клещ.
«Различие однодольных и двудольных растений» - Вопросы для повторения. Строение семени двудольных растений. Как называется корневая система у однодольных растений? Как называется корневая система у двудольных растений? Как называется вид жилкования листьев у двудольных растений? Каковы основные признаки однодольных растений? Однодольные растения. Какие виды жилкования встречаются у однодольных растений? Различия однодольных и двудольных растений. Биология, 7 класс.
«Биология Класс Птицы» - Днем спит, Ночью летает, И прохожих пугает. На болоте плачет. Экологические группы. Тимофеева Нина Николаевна учитель биологии и химии. Нет хозяин не боится. Какие утверждения верны ? Урок биологии в 7 классе. А с болота не идет. Пестрая крякуша Ловит лягушек. Органы дыхания легкие и воздушные мешки. Ночные хищные птицы. Дневные хищные птицы. Мозжечок у птиц развит плохо. Птицы леса. Ходит вразвалочку, Спотыкалочку.
«Тип Хордовые 7 класс» - Беременность. Туловищный отдел позвоночника. Жаба. О. Крокодилы. Крыло. Кл. Амфибии. Птицы. Хвостовой плавник. Плечо. Бедро. Грудные плавники. Сросшиеся туловищные позвонки. В чем стратегия выживания рыб, которые не заботятся о потомстве? Зародыш. К скелету прикрепляются мышцы. Какие роговые производные кожи имеются у пресмыкающихся и птиц? При движении тело не поднимается высоко от земли – «пресмыкание». Кишечник. Плавники.
«Класс Рыбы 7 класс» - Рассмотрите плавники рыбы. Общая характеристика надкласса Рыбы. Как по чешуйке определить возраст рыбы? Представители класса Костные рыбы. Позвоночник. Акулы. Найдите отделы тела рыбы. Обозначьте на рисунке все рассматриваемые части. Сельдь тихоокеанская. Какой смайлик показывает твоё настроение на уроке? Найдите у рыбы ноздри, глаза, боковую линию.
Всего в теме «Биология 7 класс» 149 презентаций